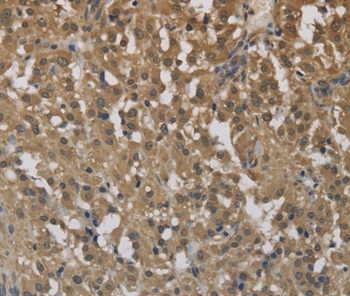
Anti-CYBA Antibody

WB analysis of various samples using GTX66756 p22phox antibody. Lane1 : MCF-7 whole cell lysate Lane2 : NIH-3T3 whole cell lysate Lane3 : PC12 whole cell lysate Dilution : 1:500
p22phox antibody
GTX66756
ApplicationsWestern Blot
Product group Antibodies
ReactivityHuman, Mouse, Rat
TargetCYBA
Overview
- SupplierGeneTex
- Product Namep22phox antibody
- Delivery Days Customer9
- Application Supplier NoteWB: 1:500-1:1000. *Optimal dilutions/concentrations should be determined by the researcher.Not tested in other applications.
- ApplicationsWestern Blot
- CertificationResearch Use Only
- ClonalityPolyclonal
- Concentration1 mg/ml
- ConjugateUnconjugated
- Gene ID1535
- Target nameCYBA
- Target descriptioncytochrome b-245 alpha chain
- Target synonymsCGD4, p22-PHOX, cytochrome b-245 light chain, cytochrome b light chain, cytochrome b(558) alpha chain, cytochrome b(558) alpha-subunit, cytochrome b, alpha polypeptide, cytochrome b-245, alpha polypeptide, cytochrome b558 subunit alpha, flavocytochrome b-558 alpha polypeptide, neutrophil cytochrome b 22 kDa polypeptide, p22 phagocyte B-cytochrome, p22phox, superoxide-generating NADPH oxidase light chain subunit
- HostRabbit
- IsotypeIgG
- Protein IDP13498
- Protein NameCytochrome b-245 light chain
- Scientific DescriptionCytochrome b is comprised of a light chain (alpha) and a heavy chain (beta). This gene encodes the light, alpha subunit which has been proposed as a primary component of the microbicidal oxidase system of phagocytes. Mutations in this gene are associated with autosomal recessive chronic granulomatous disease (CGD), that is characterized by the failure of activated phagocytes to generate superoxide, which is important for the microbicidal activity of these cells. [provided by RefSeq, Jul 2008]
- ReactivityHuman, Mouse, Rat
- Storage Instruction-20°C or -80°C,2°C to 8°C
- UNSPSC12352203